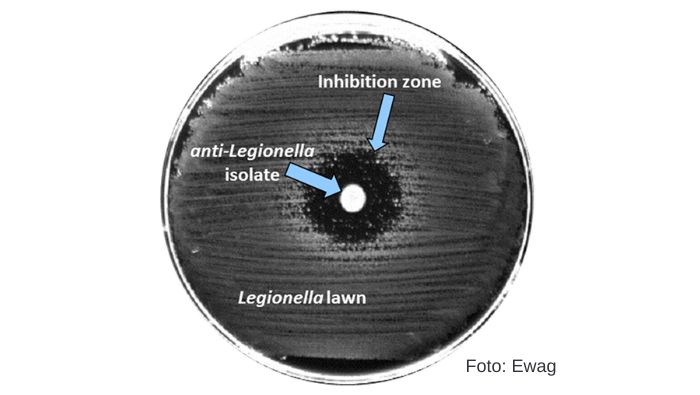

Em toda a Suíça, as infecções por bactérias do gênero Legionella estão aumentando significativamente. Pesquisadores da Eawag, já delinearam como o crescimento desses habitantes microbianos dos sistemas de água potável poderiam ser contidos, com a ajuda de outros organismos.
A Legionella são bactérias que vivem na água e podem ser encontradas em muitas tubulações de água, chuveiros, sistemas de ventilação, caldeiras e torres de resfriamento. Às vezes, elas também podem infectar as pessoas se entrarem no trato respiratório através de gotículas de água finas, por exemplo, durante o banho e desencadear legionelose. No entanto, não há necessidade de alarmismo, pois a legionelose costuma ser leve. A chamada febre de Pontiac é semelhante a uma gripe.

Embora o número de infecções por Legionella tenha dobrado nos últimos dez anos, elas ainda são relativamente raras. (Foto: peterschreibermedia/123RF.com)
Entretanto, especialmente em pessoas imunocomprometidas, a bactéria também pode desencadear um tipo de pneumonia que às vezes é fatal (conhecida como doença dos legionários). A legionelose ainda é rara, embora o número de casos tenha dobrado nos últimos dez anos para cerca de 600 infecções anuais, em toda a Suíça. “Esse aumento é motivo de preocupação”, diz Alessio Cavallaro, estudante de doutorado no Drinking Water Microbiology Group, (Suíça), liderado por Frederik Hammes.
Adição de microrganismos inofensivos
Cavallaro e seus colegas publicaram recentemente, um artigo de revisão sobre o controle probiótico da Legionella (*). “Definimos ‘probiótico’ como a adição direcionada de microrganismos inofensivos para alterar a composição microbiana do sistema e para inibir o crescimento de patógenos”, escreveram os pesquisadores em seu artigo.
Explique melhor, micróbios na água potável que é regularmente testada pelas autoridades para “segurança bacteriológica”?
Rindo, Alessio Cavallaro explica: “Nós, microbiologistas, sabemos que não existem ambientes estéreis. Uma comunidade de organismos vive na água potável e é bastante diversificada.” Essa diversidade viva coloniza as tubulações e formam em suas paredes os chamados biofilmes. Assim, as interações ecológicas entre os microrganismos vivos são quase tão diversas quanto a composição de espécies no biofilme. E é justamente aí, nesse reino, que a Legionella está em casa. “Esse micróbio não é um contaminante externo, mas parte do microbioma natural das tubulações”, acrescenta Frederik Hammes.
O ciclo de vida da Legionella, pode ser dividido em duas fases. Em conjunto com outras bactérias, a Legionella participa da formação do biofilme, onde persiste principalmente até ser absorvida por uma ameba ou outro organismo unicelular. Graças a um truque (cujos detalhes moleculares já foram desvendados), algumas Legionellas não acabam como alimento, mas se instalam em seu próprio compartimento da célula hospedeira, onde eventualmente começa a segunda fase de seu ciclo de vida.
Dentro de sua célula hospedeira, a Legionella não está apenas protegida do calor e das toxinas químicas. Elas também encontram todas as substâncias orgânicas de que precisam para se reproduzir. “Nesse aspecto, a Legionella é bastante exigente. Por exemplo, ela depende de muitos aminoácidos que não consegue sintetizar sozinha”, diz Cavallaro. A fase de reprodução e multiplicação termina quando a célula hospedeira explode, e as muitas Legionellas novas precisam encontrar um nicho novamente no biofilme.
Usando interações na complexidade do reino microbiológico
Em seu artigo, os pesquisadores relatam como esse ciclo de vida poderia ser interrompido. Por exemplo, se os protozoários já estão infectados com outras bactérias, a Legionella tem mais dificuldade em se multiplicar dentro da célula, porque precisa compartilhar os valiosos recursos da célula hospedeira com os outros invasores. Outras abordagens, também são mencionadas no artigo de revisão. Na França, por exemplo, uma empresa está avaliando amebas especiais que aparentemente não caem no truque da Legionella, e na verdade as comem em vez de deixá-las se multiplicarem dentro de si. No entanto, “evidências científicas independentes para a eficácia dessa abordagem ainda são limitadas”, advertem Cavallaro e Hammes.
Se as bactérias conseguirem repelir a Legionella com compostos tóxicos, uma zona de inibição se forma no campo da Legionella ao redor da colônia bacteriana. (Foto: Ewag)
Em seu próprio trabalho, os pesquisadores estão se concentrando, por enquanto, em outro aspecto do reino microbiológico: a capacidade de muitas bactérias produzirem compostos tóxicos, como antibióticos que inibem o crescimento de seus concorrentes, o que desempenha um papel importante nos biofilmes. Para suas investigações, os cientistas inoculam várias bactérias em placas de cultura colonizadas por Legionella em laboratório. Onde uma zona transparente se forma ao redor da gotícula com o tempo, os outros micróbios conseguiram inibir o crescimento da Legionella.
“Esperamos ser capazes de obter medidas para controlar o crescimento da Legionella a partir de tais descobertas sobre interações ecológicas”, diz Hammes. Por enquanto, essa ainda é uma perspectiva distante. Atualmente, as estratégias probióticas ainda estão longe da aplicação real em sistemas de água potável. As abordagens que se mostram promissoras nas placas de cultura bacteriana, devem ser testadas passo a passo, primeiro em frascos maiores e depois em sistemas piloto de água potável.
No entanto, os pesquisadores já estão pensando na aceitação pública de seu trabalho. “É necessária uma comunicação eficaz para deixar claro que não se trata de livrar os sistemas de água potável das bactérias, porque isso é impossível”, diz Hammes. “Em vez disso, a intenção das abordagens probióticas é mudar especificamente a natureza das comunidades bacterianas”.
Publicação Original
Cavallaro, A.; Rhoads, W. J.; Huwiler, S. G.; Stachler, E.; Hammes, F. (2022) Potential probiotic approaches to control Legionella in engineered aquatic ecosystems, FEMS Microbiology Ecology, fiac071. DOI: https://doi.org/10.1093/femsec/fiac071
Financiamento / Cooperações
- Eawag
- LeCo project (Legionella control in buildings)
- Federal Food Safety and Veterinary Office (FSVO)
- Federal Office of Public Health (FOPH)
- Federal Office of Energy (SFOE)
Links

Fonte: Eawag – Swiss Federal Institute of Aquatic Science and Technology e Ori Schipper
Adaptado por Editor – DW Journal – Digital Water